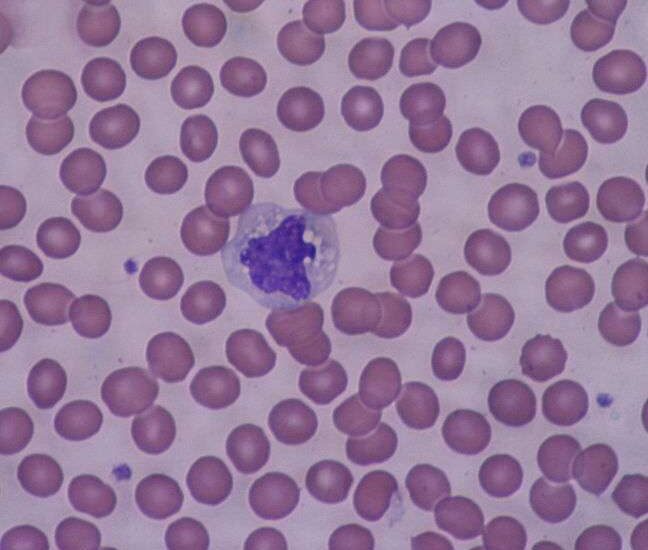

La monocytose est un terme médical utilisé pour décrire une condition dans laquelle il y a une augmentation du nombre de monocytes dans le sang. Les monocytes sont une forme de globules blancs produits dans la moelle osseuse, qui jouent un rôle important dans la réponse immunitaire de l’organisme. En cas d’infection, les monocytes se déplacent vers les tissus infectés et se transforment en macrophages pour phagocyter les micro-organismes.
Les causes
Lorsque le nombre de monocytes dans le sang est supérieur à la normale, cela peut indiquer la présence d’une infection, d’une inflammation ou d’autres troubles médicaux. Les causes de la monocytose sont nombreuses, mais les plus courantes sont les infections bactériennes, virales et fongiques. D’autres causes incluent les maladies auto-immunes, les maladies inflammatoires de l’intestin, les tumeurs malignes, le lupus érythémateux disséminé, la polyarthrite rhumatoïde et d’autres troubles du sang.
Lorsque les monocytes sont élevés, les médecins peuvent effectuer des tests sanguins supplémentaires pour déterminer la cause sous-jacente. Les tests peuvent inclure des cultures de sang pour détecter des infections bactériennes, des tests sérologiques pour détecter des infections virales et des biopsies de tissus pour détecter la présence de tumeurs malignes ou de maladies auto-immunes.
Le traitement
Le traitement de la monocytose dépend de la cause sous-jacente. Dans le cas d’une infection, des antibiotiques, des antiviraux ou des antifongiques peuvent être prescrits. Dans les cas de maladies auto-immunes, des médicaments immuno-suppresseurs peuvent être utilisés pour réduire la réponse immunitaire de l’organisme. Dans le cas de tumeurs malignes, une intervention chirurgicale, une radiothérapie ou une chimiothérapie peuvent être nécessaires.
La prévention de la monocytose implique une bonne hygiène et une surveillance régulière de la santé. Les personnes atteintes de maladies auto-immunes doivent suivre les recommandations de leur médecin pour éviter les infections et les épisodes inflammatoires. Les personnes atteintes de tumeurs malignes doivent subir des examens réguliers pour détecter toute récidive ou propagation de la maladie.
Conclusion
la monocytose est une condition médicale dans laquelle il y a une augmentation du nombre de monocytes dans le sang. Les causes de la monocytose sont nombreuses, mais les plus courantes sont les infections bactériennes, virales et fongiques. Le traitement de la monocytose dépend de la cause sous-jacente, mais il peut inclure des antibiotiques, des médicaments immuno-suppresseurs, une intervention chirurgicale, une radiothérapie ou une chimiothérapie. La prévention de la monocytose implique une bonne hygiène et une surveillance régulière de la santé.




